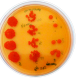

Azospirillum, la bacteria clave en la búsqueda de una agricultura sustentable
Su primera introducción en la industria agrícola, en la década de los 80s, no tuvo el impacto que se esperaba. Sin embargo, las investigaciones posteriores comprobaron los múltiples beneficios de Azospirillum sobre los cultivos. Para que sus efectos se manifiesten, es esencial la presencia de la bacteria viable y su reconocimiento por parte de las plantas.
Cuando se piensa en microorganismos benéficos para cultivos de no-leguminosas, nuestra mente suele ir a especies como Trichoderma, Bacillus, Pseudomonas…pero hay uno, igualmente ventajoso, del que no se habla mucho en la actualidad, pero tiene una larga y prolífica historia para contar, el género Azospirillum.
Este género de bacterias no simbióticas, fijadoras de nitrógeno, fitoestimulantes y multi-colonizadoras de plantas de interés agronómico, se registró por primera vez como un biofertilizante comercial en Argentina en 1996. Al mismo tiempo, los productos biológicos para el cultivo de leguminosas, como la soja comenzaban a inundar el mercado de inoculantes ya que su uso permitía descartar casi por completo el uso de fertilizantes nitrogenados. La extrapolación del uso de Azospirillum sobre cultivos como trigo y maíz, donde la dependencia a la fertilización nitrogenada no puede restringirse al 100%, determinó una comparación injusta y los productores no aceptaron la tecnología.
“Cuando se introdujo en el mercado, se la comparaba con aquellas bacterias que fijaban nitrógeno en estructuras especializadas llamadas nódulos y a través de una relación simbiótica, como ocurre en el caso de los rizobios, donde el cultivo no recibe fertilización química. Pero cuando el productor analizaba el comportamiento de la bacteria en cultivos de gramíneas pensaba que la bacteria no era tan eficiente porque debía adicionar nitrógeno como fertilizante. Así es como dejaron de utilizarla por un período de casi 20 años”, explica el Dr. Fabricio Cassán, microbiólogo y Doctor en Ciencias Biológicas por la Universidad Nacional de Río Cuarto, en Argentina.

Posicionarlo como un microorganismo benéfico requirió de mucha investigación y ensayos para que los agricultores se convencieran de sus propiedades. “Entremedio pasó mucha agua por el río y actualmente nos estamos reencontrando con el género Azospirillum, que es la segunda bacteria más utilizada en agricultura en América del Sur, luego de los rizobios”, acota el Dr. Cassán.
La especie más utilizada de éste género es Azospirillum brasilense, que hasta 2020 se consideraba como la única para uso comercial, pero luego de numerosas investigaciones, se han propuesto nuevas especies a partir de ésta, como A. baldanorium (2020) y A. argentinense (2022) ambas consideradas inicialmente como la primera.
“No queremos complicarle la vida al productor con los nombres, pero detrás de una reclasificación taxonómica, hay una comprensión funcional distinta, ya que la bacteria pertenece a otra especie y de hecho se comporta distinto”, sostiene el Investigador Principal de CONICET por el Instituto de Investigaciones Agrobiotecnológicas (INIAB).
El Dr. Cassán, quien fue parte del equipo de investigación que reclasificó A. baldanorium, y líder del equipo que reclasificó A. argentinense, explica que la segunda es muy similar a A. brasilense, pero tras realizar numerosos ensayos en laboratorio y otros en plantas de maíz, demostró su capacidad de translocación bidireccional entre raíces y la parte aérea de la planta, lo que supone un comportamiento de colonización sistémico. De ahí la importancia de la reclasificación taxonómica, que permite explicar distintos comportamientos y efectos de ésta bacteria en los cultivos.

GENERALIDADES DE AZOSPIRILLUM
Desde que fue identificada, Azospirillum se definió como una colonizadora generalizada de las plantas. “Básicamente puede colonizar todo lo que tenga enfrente y que sea verde. Llamemos colonizar no a que la bacteria sobrevive cuando la ponemos en la planta, sino que coloniza, se multiplica y a lo largo del tiempo la podemos recuperar de esa planta”, indica el especialista. La mayoría de las especies del género Azospirillum que se han caracterizado, se han obtenido de suelo agrícola o plantas y esto se explica desde la evolución, considerando que este microorganismo realizó la transición con las plantas desde ambientes acuáticos a terrestres.
Con el paso de los años han salido cada vez más informes, reportes y publicaciones sobre éste género, lo que ha permitido que se generen más productos comerciales. “Es importante que se siga estudiando y analizando las publicaciones recientes, porque éstas respaldan la tecnología. En este sentido, hay que ser muy cuidadosos sobre cómo manejamos las tecnologías novedosas, cuando éstas no están respaldadas o sustentadas con información técnica”, señala el microbiólogo.
Para explicar su importancia en agricultura, en 2022, se usaron un total de 23,5 millones de dosis de producto conteniendo Azospirillum como principio activo, en más de 23 millones de hectáreas entre Brasil, Argentina y Uruguay. Esto incluye el tratamiento de semillas de maíz, soja y otras leguminosas como maní y poroto, además de trigo, sorgo, girasol, y otras especies hortofrutícolas. Lo anterior ha posicionado a Azospirillum como el segundo género más usado en agricultura en Sudamérica, fuera del sistema soja.
En cuanto a sus beneficios directos sobre los cultivos, el aumento en el rendimiento inoculando con Azospirillum va entre un 4% y un 14%, con un mayor porcentaje en cereales de invierno como el trigo, y menos en los cereales de verano como el maíz. Además, posee una alta compatibilidad con rizobios en general y leguminosas. “La coinoculación de leguminosas con rizobios y Azospirillum es una práctica que en la actualidad puede llegar a duplicar los rendimientos tras la inoculación solo con rizobios”.
La frecuencia de éxito documentada de la inoculación con Azospirillum es mayor al 80%, comparable al porcentaje de inoculación que ocurre con la soja. En términos de retorno económico al productor, este varía entre US$15/ha y US$30/ha respecto al costo por dosis de producto formulado con esta bacteria.
2020, EL AÑO QUE MARCÓ UN ANTES Y UN DESPUÉS
A partir de 2020, varios grupos de investigación, especialmente en Brasil, comenzaron a entender la funcionalidad de Azospirillum como una tecnología que potencialmente permitiría reducir la aplicación de fertilizantes químicos nitrogenados. Uno de estos estudios, liderado por la reconocida investigadora brasileña Mariangela Hungria, obtuvo como resultado que la inoculación con Azospirillum permitiría reemplazar la fertilización nitrogenada hasta en un 25%, con un ahorro de hasta US$15/ha al productor. “Y algo que para mí es importantísimo y lo veo por primera vez en este trabajo, es cuánto se reporta la reducción en la emisión de CO2 en 236 kg/h. Un impacto económico y ambiental positivo. Este tipo de trabajos son los que determinaron que en la actualidad se vuelva a utilizar esta bacteria en agricultura extensiva”, apunta Cassán.
Otro estudio que mostró el Dr. Cassán consideró la evaluación, no solo de nitrógeno, sino de otros macroelementos como fósforo y potasio, que tras la inoculación aumentaron en los tejidos vegetales por su absorción en un 20%, 24% y 19% respectivamente. El mismo efecto se dio a nivel del estado hídrico de la planta, el que mejoró luego de la inoculación y se explica por la mejora en la absorción del elemento desde el suelo.
En un trabajo realizado en el cultivo de trigo, se analizó la acumulación de microelementos, tanto en tejido vegetativo como en granos. “La capacidad benéfica de la bacteria no pasa solo por la fijación de nitrógeno o el metabolismo del nitrógeno; la planta está tomando más nutrientes y agua desde el suelo cuando está inoculada”. La inoculación con A. brasilense permitió una mayor acumulación de cobre, hierro, manganeso y zinc en tejido vegetativo, así como de manganeso y zinc en granos.
AZOSPIRILLUM SP., UN MODELO DE RIZOBACTERIA FIJADORA DE NITRÓGENO NO SIMBIÓTICA
Desde el redescubrimiento del género en la década del 70 por la investigadora Johana Döbereiner en Brasil -de la que se cumplen 100 años de su natalicio en 2024-, el género se asoció a dos mecanismos de promoción del crecimiento vegetal: la fijación de nitrógeno y la producción de fitohormonas.
El primer mecanismo lo realiza en condiciones de vida libre, sin producir nódulos ni generar simbiosis, por lo que la tasa de fijación comparativa a la de una simbiosis es más baja. Cuando investigadores de distintas partes del mundo comenzaron los estudios para determinar cómo fijaba el nitrógeno, se llevaron una sorpresa. Un estudio en que inocularon plantas con A. brasilense mutante en el gen de la nitrogenasa (nifH), es decir, que no fija nitrógeno, mostró la misma respuesta de crecimiento que la cepa salvaje ‘fijadora de nitrógeno’.
“Hicieron otro tipo de ensayos para tratar de determinar cuánto nitrógeno fijaba y fue menos de lo que esperaban, pero nunca se desestimó la fijación de nitrógeno como un mecanismo de promoción de crecimiento. Por alguna razón la fijación de nitrógeno se mantuvo en el tiempo, porque los ensayos muestran que, de alguna forma, la planta adquiere más nitrógeno cuando la inoculas con Azospirillum”, señala el Dr. Cassán.
Azospirillum es además una bacteria fitoestimuladora con capacidad de producir fitohormonas como auxinas, giberelinas, citoquininas, etileno, por mencionar algunas, donde las más estudiadas son las primeras. La producción de ácido indolacético (AIA) y su efecto primario se observa a nivel de la arquitectura de las raíces de las plantas inoculadas, donde hay un aumento muy significativo del área de absorción radicular por la disminución de la longitud de la raíz principal y el aumento en longitud y cantidad de las raíces secundarias y longitud de pelos absorbentes.
SU INFLUENCIA EN LA RAÍZ
“Para la mayoría de las plantas, la raíz es el órgano de mayor crecimiento, pero a los agrónomos y productores, les encanta ver lo que está por encima del suelo. Pero…¿Qué pasa en la raíz? Este órgano controla el estado hídrico de la planta, la nutrición mineral y las interacciones bióticas, con la parte viva del suelo”, apunta Cassán sobre la importancia de poner el foco bajo tierra. El experto además mencionó un modelo común desde la fisiología, donde algunas plantas, en condiciones de estrés hídrico acortan su sistema radicular y aumentan el desarrollo secundario como una estrategia para aumentar el área de absorción, “a diferencia de lo que uno creería que pasa, que hay que explorar para encontrar agua”.

En pocas palabras, la literatura generada en todos estos años, sobre el efecto de Azospirillum en el desarrollo radicular, es muy amplia y en ella se resume que, por presencia de la bacteria las plantas mejoran la absorción de nutrientes y agua desde el suelo, gracias al aumento de tamaño o superficie de la raíz; aumento del número y longitud de raíces laterales; aumento de la producción de biomasa radical; aumento del número y densidad de pelos radiculares; aumento de la división celular en el meristema y arreglos celulares en la corteza; y un aumento de la producción de exudados. “Todos estos son reportes publicados por cientos de investigadores en todo el mundo que han tratado de explicar de diferente manera los efectos de la inoculación con Azospirillum a nivel de raíz y de qué manera benefician a la planta”, indica el experto.
Antiguamente se creía que por ser una bacteria de vida libre y no establecer una simbiosis, la planta no reconocía a Azospirillum cuando se inoculaba, pero actualmente se ha demostrado que cuando las bacterias producen ciertas estructuras celulares o algunos metabolitos con actividad biológica (fitohormonas), la planta sí los reconoce y cambia su programa de crecimiento por ser estimulada a crecer. “Así, la planta ‘entiende’ que la bacteria que está presente es benéfica y el efecto de las hormonas que ella produce afectan el desarrollo de la planta. Así, cuando la planta reconoce a ciertas bacterias, su predisposición a crecer se expresa de manera positiva. Es como si entendiera el medioambiente benéfico a través de la presencia de Azospirillum”, sostiene Cassán.
Un estudio realizado por el grupo del microbiólogo en 2024, en el que tenían como control una planta de Arabidopsis thaliana inoculada con A. argentinense Az39, y otra mutante en el gen que controla la síntesis de auxinas, llamada Az39 ipdC-, demostraron que la producción de pelos radiculares no dependía de las fitohormonas, en este caso, auxinas, producidas por la bacteria, sino de la presencia física del microorganismo en interacción con la planta. Las fitohormonas solo controlaban la arquitectura radical a nivel de la reducción de la raíz principal y aumento del número y longitud de las raíces laterales.

CONSIDERACIONES FINALES
El Dr. Cassán sostiene que Azospirillum es uno de los géneros más estudiados y un soporte de información extenso, con prácticas consolidadas relacionadas a su aplicación en agricultura. Su impacto en los cultivos depende de la capacidad bacteriana de modificar la absorción de agua y nutrientes por la raíz. Además, subrayó la capacidad fitoestimulante de la bacteria y que la presencia de ésta, es esencial para lograr el efecto rizoestimulante a nivel de los pelos radiculares.
“Podemos reducir la fertilización química nitrogenada aplicando la bacteria”, dice, en promedio hasta un 25% dependiendo de factores como el cultivo, tipo de fertilizante, condiciones ambientales, entre otros. Esto además permite ahorrar dinero, en el orden de US$15/ha, lo que se traduce en US$1,2 billones al año en la economía global debido a la reducción de la fertilización nitrogenada.
Los efectos ambientales también permiten mejorar el tipo de agricultura que se practica en términos de sustentabilidad, evitando la emisión a la atmósfera de 236 kilos de CO2 por hectárea al año. “Eso es porque las plantas, en general, en presencia de la bacteria, hacen más eficiente la toma de recursos desde el suelo, no solo los macro y micronutrientes, sino también el agua”.
Gracias a las características mencionadas en este artículo, entendemos que Azospirillum es una herramienta esencial para generar un cambio de paradigma en la agricultura moderna, por la reducción en la aplicación de fertilizantes y la producción de manera más eficiente y sustentable.







